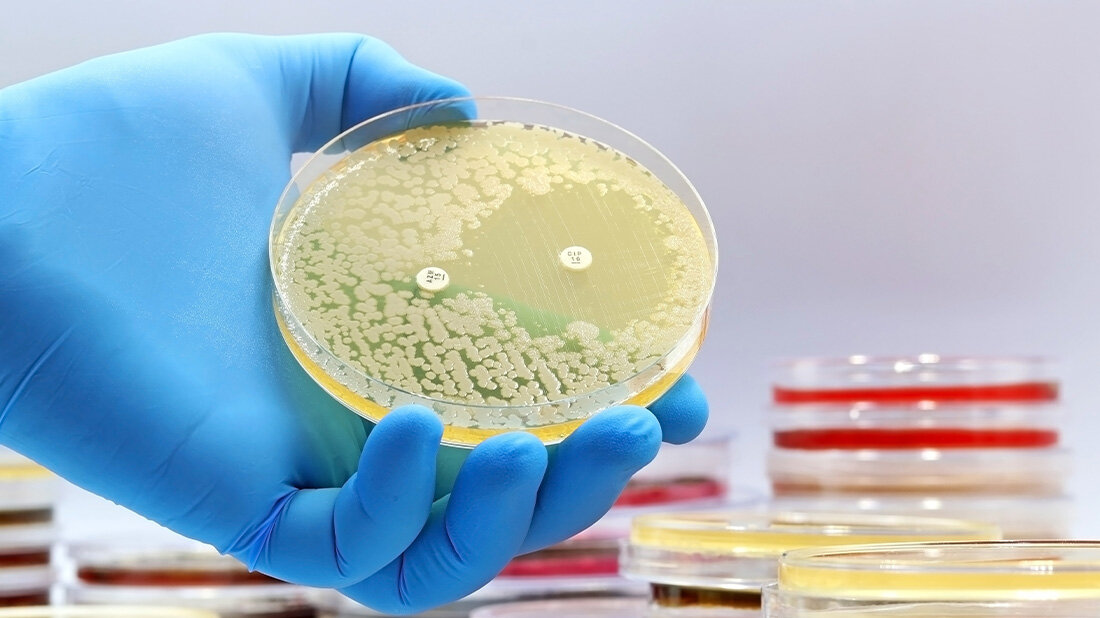
RKI hat Daten zur Antibiotikaresistenz und zum Antibiotikaverbrauch aktualisiert

Eine positive Entwicklung zeichnet sich laut RKI für die Resistenz gegenüber Vancomycin bei E. faecium aus Blutkulturen ab: Hier liegt der Resistenzanteil mit 18,1 Prozent zum ersten Mal seit 2018 unter der Marke von 20 Prozent. Bei Stapylococcus aureus setzt sich den Daten zufolge der seit Jahren beobachtete Rückgang der Methicillinresistenz fort: der Anteil von MRSA liegt 2022 bei 7,1 Prozent in allen Proben aus stationärer Versorgung bzw. 3,8 Prozent in der ambulanten Versorgung, sowie bei 4,0 Prozent in Isolaten aus Blutkulturen.
Resistenz gegenüber Carbapenemen
Bei den gram-negativen Erregern liegt das besondere Augenmerk auf der Resistenz gegenüber Carbapenemen: Für die häufigsten Enterobacterales – Klebsiella pneumoniae, Klebsiella oxytoca, Enterobacter cloacae, Citrobacter freundii – liegt der Anteil von carbapenemresistenten Isolaten in der stationären Versorgung überall unter einem Prozent; bei E. coli wurde Carbapenemresistenz nur bei vereinzelten Isolaten nachgewiesen. Für die Nonfermenter liegt die Carbapenemresistenz in der stationären Versorgung auf etwas höherem Niveau: für Acinetobacter baumannii complex bei 5,9 Prozent (Vorjahr: 3 Prozent) und für Pseudomonas aeruginosa nahezu unverändert gegenüber dem Vorjahr bei 5,4 Prozent.
Umfangreiche Datengrundlage
Für das Berichtsjahr 2022 liegen Daten aus 724 Einrichtungen der stationären Versorgung vor, darunter 591 Allgemeine Krankenhäuser; dies entspricht einer coverage von 34,5 Prozent bei den Allgemeinen Krankenhäusern (Anteil von Allgemeinen Krankenhäusern in ARS an allen Allgemeinen Krankenhäusern laut Krankenhausstatistik). In der ambulanten Versorgung deckt ARS mit Daten aus 21.950 Arztpraxen 29 Prozent der Praxen in Deutschland 2022 ab. Eine interaktive Abfrage der Daten ist unterars.rki.de möglich.
Antibiotika-Verbrauchs-Surveillance
Auch die Antiinfektiva-Reports auf der Antibiotika-Verbrauchs-Surveillance-Website (AVS-Website) wurden auf den neuesten Stand gebracht. Dort stehen Antibiotikaverbrauch für die Jahre 2015 bis 2022 zur Verfügung, für das Jahr 2022 haben erneut über 200 Krankenhäuser Daten beigetragen. Eine interaktive Abfrage kann unter avs.rki.de erfolgen.
Quelle: RKI
Artikel teilen